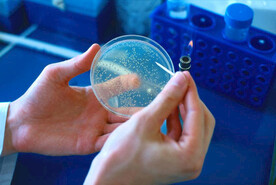
半导体科技

-
 时间 共享分:
时间 共享分:40 -
 数据通信 共享分:
数据通信 共享分:40 -
 半导体科技 共享分:
半导体科技 共享分:40 -
 数码科技 共享分:
数码科技 共享分:40 -
 网络科技 共享分:
网络科技 共享分:40 -
 数码科技 共享分:
数码科技 共享分:40 -
 数码科技 共享分:
数码科技 共享分:40 -
 数码科技 共享分:
数码科技 共享分:40 -
 无线通信 共享分:
无线通信 共享分:40 -
 数码科技 共享分:
数码科技 共享分:40 -
 数码科技 共享分:
数码科技 共享分:10 -
 半导体科技 共享分:
半导体科技 共享分:40 -
 网络通讯 共享分:
网络通讯 共享分:10 -
 数据通讯 共享分:
数据通讯 共享分:40 -
 数码科技 共享分:
数码科技 共享分:40 -
 数字通信 共享分:
数字通信 共享分:40 -
 数码科技生活 共享分:
数码科技生活 共享分:40 -
 数码通讯 共享分:
数码通讯 共享分:40 -
 数码科技 共享分:
数码科技 共享分:40 -
 数字科技 共享分:
数字科技 共享分:40 -
 数码科技 共享分:
数码科技 共享分:40 -
 数码科技 共享分:
数码科技 共享分:40 -
 数码通讯 共享分:
数码通讯 共享分:40 -
 数码通讯 共享分:
数码通讯 共享分:40 -
 数码科技 共享分:
数码科技 共享分:40 -
 数码科技 共享分:
数码科技 共享分:40 -
 数码科技 共享分:
数码科技 共享分:40 -
 网络科技 共享分:
网络科技 共享分:40 -
 数字通信 共享分:
数字通信 共享分:40 -
 数字科技 共享分:
数字科技 共享分:40
Copyright © 2025 NiPic.cn All Rights Reserved 版权所有·昵享网 昵享网是网络服务平台方,若您的权利被侵害,请联系 copyright@nipic.cn
浙ICP备2022002922号-1 增值电信业务许可证:浙B2-20220223 违法和不良信息举报电话:0571-89267010